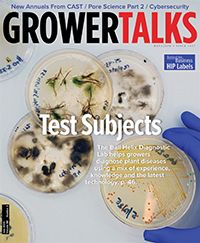

When a Seed Deserves a Brand
Sunfinity® is a fundamental shift in the industry’s attitude toward sunflowers. Before, ideal sales ran along the Mammoth model: tall thick stems with single massive flowers. In the garden, it was a bunch of anticipation leading up to the ultimate grand event.
Mammoths are once and done with a big ta-da, but Sunfinity lights up a new path. Imagine a sunflower bush blooming most of the summer. It can do jobs Mammoth can’t touch.
Yellow Dark Center launched the Sunfinity brand, moving the sunflower category into new job roles. The product as you see it took about two decades to develop, from its discovery as a curiosity in a breeding trial to its launch at CAST.
The Full Sunfinity Package
A significant difference is the plant’s desire to rebranch. This behavior converts it from a telephone pole to a cloud of color capable of filling space. Bear in mind, Sunfinity does want to grow upward first before it begins to branch. Although pinching isn’t required, it helps the laterals set out earlier and controls some of the vigor. Pinching technique determines the style of the product.
Another big deal is Sunfinity’s need to rebloom again and again. The plant reblooms simultantously (many flowers at once) to create the color effect. Then, over time, a bushy bed of sunflowers reblooming builds a reasonable color season for mid-to-late summer.
Vigor sets it apart. Sunflowers are strong growers but Sunfinity has extra oomph to back up all that activity. The series requires separate protocols than those for the standard helianthus crop—that’s how unique Sunfinity is.
Branching is part of the not-so-secret sauce behind the series. Combined with reblooming (to lengthen the season) and vigor (to support it all), Sunfinity redefined how growers could finish a sunflower and how retail/landscape could deploy it.
Expanding the Revenue Footprint
Taken together, the full package means a bushy sunflower with a much longer bench life for a retail product growing in a nursery pot. These changes make the garden payoff different, as well. Traditional varieties are grown to achieve a celebration of a massive seedhead. With Sunfinity, a season full of sunflowers can be enjoyed.
This is a paradigm shift in how the product is received by the public. It also changes the way trade professionals use the plant as a serious tool to achieve results. For example, Sunfinity can provide summer display color for commercial accounts whereas traditional varieties can't touch that market.
Late summer is always a problem when it comes to sourcing reliable color. Sunfinity allows sunflowers to compete for late summer work with steady color displays, and it has a financial upside. Seed product and big plants mean lower costs to fill that square foot color vis-à-vis vegetative material.
Another market Sunfinity can address is cut flower production for bouquets. It behaves like the zinnia of sunflowers with a cut-and-come-again quality. Rebranching means multiple flowerheads from the same planting, and reblooming means multiple cuttings over time.
Double Yellow is the one with the fuzzy center. It’s not not offered as seed, but cuttings. This style of input strengthens the sunflower for the southern lifestyle.
Extending the Brand
Between discovery and launch, it took over 10 years to shake out the unwanted genes and bake in the desirable traits to ship quality seed. It also took a long time to dial in the protocols for good bonzai rates, when to pinch it, what happens when you don’t, dealing with day length sensitivity, and which PGRs to use plus their timing.
Pulling all this together, Sunfinity launched as a single cultivar in 2017. Eight years later, it expanded into a brand family with a total of three cultivars:
- Yellow Dark Center is the original that redefined the category, offered as seed.
- Double Yellow fuzzes out the center eye to create the fluffy style of sunflower. Offered as cuttings, it was introduced to the trade last year, so retail plants are reaching gardens this year.
- Bicolor Yellow-Red is a bicolor riff off of Yellow Dark. A seed product, it just became available to the trade this year. Plants grow just a touch shorter than Yellow Dark, but have similar characteristics otherwise.
Notice the bushy nature of the green canopy under the Sunfinity blooms as it appears in a landscape display (right) and a decor product (left background).
Regional Variations
Sunflowers are true annuals. The first couple of flushes are nice and big, but as the plant continues through life and gets more branches, the flowers get smaller until they eventually peter out altogether. Once it goes through its life cycle, even in perfect conditions, it’s done.
For this reason, Syngenta promises about 9 to 12 weeks of performance. That nine weeks comes from the South, where the climate burns through the plant’s internal fuel just a little bit faster. Southern heat and light speed Sunfinity up so when it runs out of gas, that’s it.
This is why Southern growers want Sunfinity Double, the cultivar available as cuttings. They like it more because vegetative matter ages differently. It doesn’t get quite the same seed annual life cycle attached to it, so it keeps better in the heat and holds up better over time. Cuttings are clones, so they retain some of the quirks unique to the individual that don’t get passed into seed. You’ve seen it with seed and vegetative petunias, seed and vegetative geraniums, and now with seed and vegetative Sunfinities.
Bicolor Yellow-Red is new to the trade this year. Offered as seed, this cultivar is a touch shorter than Yellow Dark Center but otherwise the same.
Popular Articles
